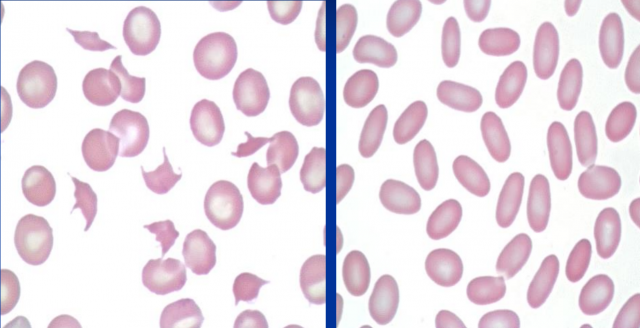
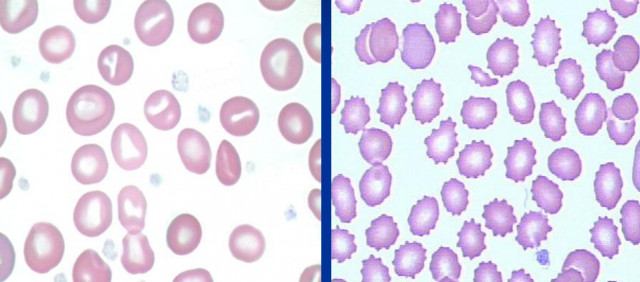

ПРОВЕДЕНО ПЕРШЕ ЗАНЯТТЯ У НОВОМУ НАВЧАЛЬНОМУ РОЦІ З ДИСЦИПЛІНИ ПАТОФІЗІОЛОГІЯ ТВАРИН НА КАФЕДРІ ХІРУРГІЇ І ПАТОФІЗІОЛОГІЇ ІМ. АКАД. І. О. ПОВАЖЕНКА
Сьогодні 15 серпня проведено перші пари лабораторних занять з дисципліни патофізіологія тварин, які відкривають навчальний рік, який неможливий без очного навчання, щоб сформувати справжнього лікаря ветеринарної медицини.

Під час проведення навчальних практичних занять студенти відпрацювали методику дослідження патології крові тварин, а саме: визначення кількісних та якісних змін еритроцитів; вивчали показники крові за анемії; визначення кількісних та якісних змін лейкоцитів; механізми зсідання крові; зміни еритроцитів за різної патології; лейкоз – етіологія, патогенез та класифікація.


За допомогою викладачів кафедри хірургії та патофізіології імені академіка І. О. Поваженка старшого викладача Бокотька Р. Р. та Савчук Т. Л. вивчали морфологічні аномалії еритроцитів (кроля, корови, коня, собаки, кішки).

Вивчали виникнення гіпохромії, анізоцитозу, мікросфероцитоз еритроцитів, спадковий овалоцитоз, стоматоцитоз, акантоцитоз, мішенеподібні еритроцити, анізопойкілоцитоз. Проводили експериментальний метод механічного гемолізу, також спостерігали шлемоподібні еритроцити.
Також експериментально спостерігали та вивчали у мазку крові – макроцитоз, пойкілоцитоз, гіперхромію.
Кандидат ветеринарних наук,
старший викладач,
заступник директора НДІ здоров’я тварин
з питань студентської наукової роботи
Бокотько Роман Романович
